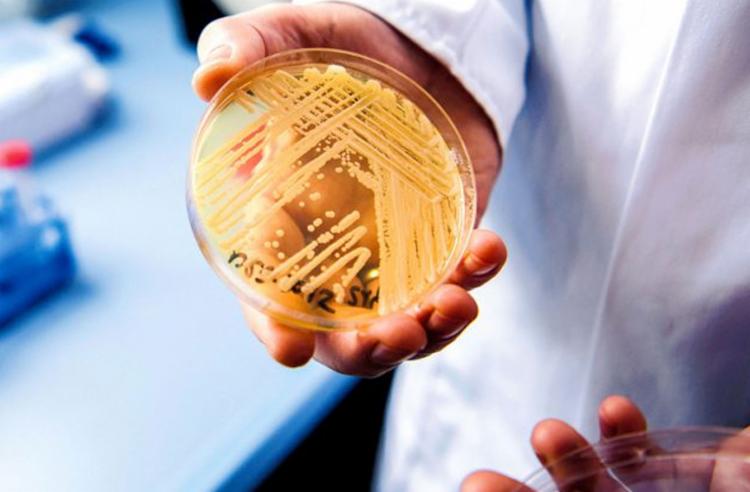

Superfungo identificado em Salvador mata 39% dos contaminados, aponta pesquisa
Superfungo identificado em Salvador mata 39% dos contaminados, aponta pesquisa
O superfungo Candida auris, que foi identificado pela primeira vez no Brasil em Salvador nesta segunda-feira, 7, pode ter uma taxa de mortalidade acima de 30%. É o que aponta um artigo da BMC Infectious Diseases, que mostra que ele possui uam taxa de mortalidade de 39%.
Ainda de acordo com estimativas publicadas por pesquisadores chineses na BMC Infectious Diseases em novembro, há ao menos 4,7 mil casos de infecção pela Candida auris já registrados em 33 países. A Secretaria da Saúde da Bahia (Sesab) informou que está acompanhando o caso.
Na terça-feira, 8, a Agência Nacional de Vigilância Sanitária (Anvisa) chegou a emitir um alerta nesta terça-feira, pontuando que o Candida auris é "um fungo emergente que representa grave à saúde global" e que algumas cepas dele são resistentes a todas as principais classes de fármacos antifúngicos.
Em seu alerta, a Anvisa apontou que, além da multirresistência e do risco de "ser fatal, principalmente em pacientes com comorbidades", a Candida auris apresenta ainda o obstáculo de "permanecer viável por longos períodos no ambiente (semanas ou meses)" e apresentar "resistência a diversos desinfetantes" usados nos hospitais
Candida auris chama atenção por ser especialmente resistente aos tratamentos disponíveis contra a candidíase. A boa notícia é que o superfungo costuma se restringir aos ambientes hospitalares e não é tão contagioso quanto outros patógenos, como o vírus SARS-Cov-2, causador da Covid-19, por exemplo.
Com informações do A Tarde
 Saúde Ampolas de “mounjaro paraguaio” entram na Bahia por contrabando e abastecem mercado paralelo
Saúde Ampolas de “mounjaro paraguaio” entram na Bahia por contrabando e abastecem mercado paralelo  Saúde Após recomendação do MP, secretário diz que Prefeitura já adequou TFD às normas e ampliou estrutura do serviço em Feira
Saúde Após recomendação do MP, secretário diz que Prefeitura já adequou TFD às normas e ampliou estrutura do serviço em Feira  Palavra de médico Junho Violeta: O “Palavra de Médico” deste domingo (14) alertou para violência contra idosos e combate mitos sobre o envelhecimento
Palavra de médico Junho Violeta: O “Palavra de Médico” deste domingo (14) alertou para violência contra idosos e combate mitos sobre o envelhecimento  Contaminação Comissão confirma incidente com material radioativo em São Paulo
Contaminação Comissão confirma incidente com material radioativo em São Paulo  Saúde Uso indiscriminado de corticoides pode causar glaucoma, catarata precoce e até cegueira irreversível, alerta oftalmologista
Saúde Uso indiscriminado de corticoides pode causar glaucoma, catarata precoce e até cegueira irreversível, alerta oftalmologista  Saúde 14ª Conferência Municipal de Saúde reúne gestores, trabalhadores e usuários para discutir o fortalecimento do SUS em Feira
Saúde 14ª Conferência Municipal de Saúde reúne gestores, trabalhadores e usuários para discutir o fortalecimento do SUS em Feira 
Mín. 18° Máx. 25°
Mín. 18° Máx. 27°
Chuvas esparsasMín. 16° Máx. 28°
Tempo limpo







